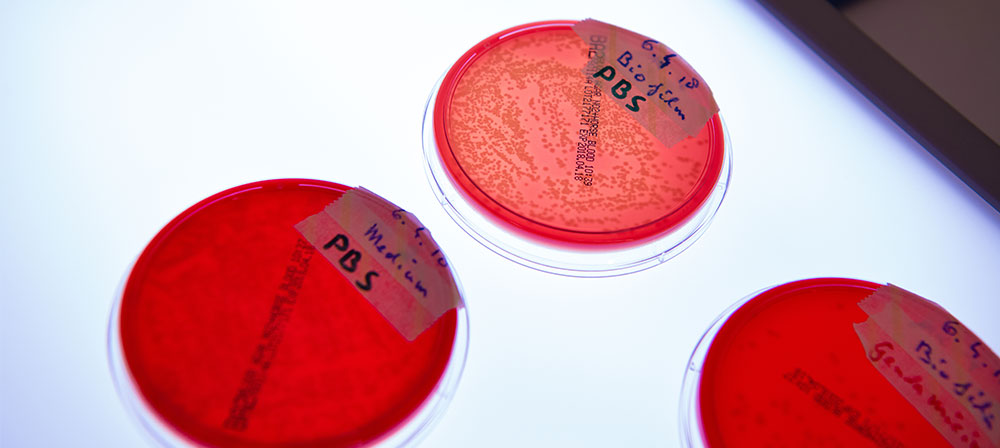

Infection studies
Understanding the pathogenesis of musculoskeletal infection and developing customized interventions
In vitro testing
- Antimicrobial efficacy testing of anti-infective surfaces
- Bacterial adhesion and biofilm formation on test materials
- Imaging of test surfaces with or without bacteria/biofilm using Scanning Electron Microscopy (SEM)
- Biobank of clinical bacterial isolates from patients with bone and implant infection
Animal models
- Mouse, rat, rabbit, and sheep models of infection prevention
- Rat, rabbit, and sheep models of infection treatment
- Experience in working with antibiotic resistant pathogens (eg, MRSA)
- Systemic and local application of antibiotics/antimicrobials histological preparation
- Histological analysis of infected tissues with bacteria-specific staining
Analysis
- Determining antimicrobial efficacy of specific devices or biomaterials
- Quantitative bacteriological analysis of biological specimens including bone
- Quantitative analysis of explanted hardware
In vivo models of infection at ARI, l-r: mouse femoral plate, rabbit humeral nail, rabbit humeral LCP, rat tibial screw, sheep tibial nail
Intraoperative image showing fixation of the humerus with an LCP in our rabbit model of fracture-related infection
False colored scanning electron micrograph of a biofilm formed by Staphylococcus aureus on implant surface, showing fibrin formation in red
Qualifications
- Microbiologists (PhDs) experienced in infection studies
- PhD level scientists and experienced project leaders
- Highly qualified technicians
Certification
- ISO 9001:2015
- Good Laboratory Practice (GLP)
Contact

Ulrich Bentz
AO Research Institute Davos
Clavadelerstrasse 8
7270 Davos Platz
Switzerland
Tel.: +41 81 414 23 26